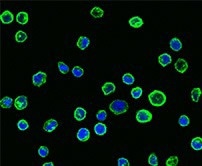
Immunofluorescence staining of CD58 in Raji cells.

The glycoprotein CD58 acts as a costimulatory receptor, with its natural ligand, CD2, primarily found on the surface of T and NK cells. The interaction between CD2 and CD58 is critical for forming the immunological synapse, which is pivotal in immune cell activation and adhesion, as well as signaling in both immune and target cells.
Recent research has underscored the importance of the CD2-CD58 axis in cancer immunotherapy, indicating its potential to bolster anti-tumor immunity, thereby making it a promising target for therapeutic interventions. The CD2-CD58 axis also plays a role in the regulation of autoimmune diseases, tumor immune evasion, antiviral responses, and immune rejection.
Targeted therapies have been developed to exploit this axis. For example, Siplizumab, a monoclonal antibody targeting CD2, shows promise for treating type 1 diabetes and transplant rejection. Additionally, Alefacept, which targets CD2, has already been approved for treating psoriasis. Sino Biological provides a comprehensive range of recombinant CD2 and CD58 proteins and antibodies to facilitate the exploration of these crucial interactions and pathways, potentially leading to novel therapeutic strategies.
Physiological and pathological roles
CD2, primarily present on T cells and NK cells, engages with CD58 (LFA-3) on antigen-presenting cells such as dendritic cells and macrophages. This CD2-CD58 interaction is crucial for immune cell activation and adhesion, playing a significant role in forming the immunological synapse, which is vital for effective immune responses.
Dysregulation of the CD2-CD58 axis is associated with autoimmune diseases, transplant rejection, and certain cancers. Targeting this axis holds promise for cancer immunotherapy, as it can enhance T-cell responses against tumors and may help overcome resistance to immune checkpoint blockade therapies.

Role of CD2-CD58 interactions in clinical antitumor T cell responses. Image Credit: Sino Biological US Inc.
Bench to bedside
The CD2-CD58 axis is pivotal in immune function and is a key target for developing new disease treatments, especially for cancers. A recent study by Ho et al. demonstrated that this axis can be exploited to activate CD28-CD8+ T-cells in cancer immunotherapy. By disrupting the regulation of the PD-L1 protein by CMTM6, this activation enhances anti-tumor immunity, making cancer cells more vulnerable to immune attacks, particularly in cases resistant to conventional anti-PD-1 therapy.
Efforts to target the CD2-CD58 axis are ongoing in clinical trials. For example, Siplizumab, a monoclonal antibody against CD2, is in phase 2 trials for treating type 1 diabetes and transplant rejection. Additionally, Alefacept, which targets a different pathway, has been approved for psoriasis treatment, highlighting the potential of targeted immunotherapy.
Table 1. (Pre) Clinical status of agents targeting CD2 and CD58. Source: https://www.pharnexcloud.com/
| Molecule |
Drugs |
Clinical Status |
Conditions |
| CD2 |
UCART-2 |
Pre-clinic |
Sezary symptom, T cell lymphoma |
| EV-104 |
Pre-clinic |
Bladder tumor, lung tumor |
| EPC-001 |
Pre-clinic |
ALL, B cell lymphoma |
| siplizumab |
Phase II |
Type 1 diabetes, transplant rejection |
| alefacept |
On Market |
Psoriasis |
| CD58 |
SBT-11-5301 |
Pre-clinic |
Type 1 diabetes, autoimmune disease |
| EVOLVE-105 |
Pre-clinic |
B-cell lymphoma, non-Hodgkin's lymphoma |
| rilimogene galvacirepvec |
Phase II |
Prostate cancer |
| inalimarev + falimarev |
Phase II |
Bladder cancer, colon cancer |
Application in research
Sino Biological's products are frequently cited in prestigious journals. For instance, Binder et al. utilized recombinant human CD2 from Sino Biological to study the binding dynamics between Siplizumab and CD2 using an SPR assay.
In another study, Miao et al. investigated the relationship between CMTM6 and CD58 expression in human cancers through IHC analysis, employing a validated anti-CD58 antibody (Cat#: 12409-R126, Sino Biological). Furthermore, Hamid et al. demonstrated a time-dependent increase in CD61 and CD103 at the contact points between the T cell membrane and the bilayer, using total internal reflection fluorescence microscopy with lipid bilayers coated with ICAM-1, E-cadherin, and CD58 proteins from Sino Biological.

Affinity of different anti-CD2 antibodiesfor CD2 (Sino Biological) and Fc gamma receptor (FcγR) I, IIA, and IIIA. The KD values were measured with surface plasmon resonance. https://doi.org/10.3389/fimmu.2021.599526.

Sequential sections from tumor biopsies of three melanoma patients (B) and three colon cancer patients (C) were stained for CMTM6 and CD58 (Cat#: 12409-R126, Sino Biological), showing co-localization of CD58 with CMTM6. https://doi.org/10.1016/j.ccell.2023.08.008

(c) Histograms display the median fluorescence intensity (MFI) of antigen (HLA-A2NY-ESO-1, blue), CD103 (yellow), CD61 (magenta), and TCR (green) on lipid bilayers coated with ICAM-1, E-cadherin, and CD58 proteins (Sino Biological), relative to maximum MFI at 15 minutes, at distances from the synapse center (5, 10, 15 minutes post synaptic formation). (d) Dot plots show MFI of CD61, CD103, and TCRαβ at synapse contacts, at 5, 10, and 15 minutes post synaptic formation with lipid bilayers coated with ICAM-1, E-cadherin, and CD58 proteins (Sino Biological). https://doi.org/10.1038/s41590-024-01802-3
Featured recombinant CD2 and CD58 proteins
- HPLC-verified
- Activity-validated
- Broad Coverage of Species and Tags
Human CD2 protein (hFc tag)
Validated activity (Cat#: 10982-H02H)

Functional ELISA: Immobilized human CD58-His (Cat#: 12409-H08H) can bind human CD2-Fc. Image Credit: Sino Biological US Inc.
Cynomolgus CD2 protein (His tag)
HPLC-verified (Cat#: 90300-C08H)

Purity: ≥90 % as determined by SDS-PAGE and SEC-HPLC. Image Credit: Sino Biological US Inc.
Human CD2 protein (His tag)
HPLC-verified (Cat#: 10982-H08H)

Purity: ≥97 % by SDS-PAGE and ≥ 95 % SEC-HPLC. Image Credit: Sino Biological US Inc.

Functional ELISA: Immobilized human CD2 His can bind human CD58 hFc (Cat#: 12409-H02H). Image Credit: Sino Biological US Inc.
Human CD58/LFA-3 protein (hFc tag)
HPLC-verified (Cat#: 12409-H02H)

Purity: ≥ 95 % by SDS-PAGE and ≥ 85 % SEC-HPLC. Image Credit: Sino Biological US Inc.

Functional ELISA: Immobilized human CD2-His (Cat#: 10982-H08H). Image Credit: Sino Biological US Inc.
Featured antibodies against CD2 and CD58
Anti-CD58/LFA-3 antibody, rabbit mAb
(Cat#: 12409-R126)
Application: IHC-P

Immunochemical staining of human CD58 in human appendix. Image Credit: Sino Biological US Inc.
Anti-CD58/LFA-3 antibody, rabbit mAb
(Cat#: 12409-T50)
Applications: WB, ELISA, ICC/IF
Immunofluorescence staining of CD58 in Raji cells. Image Credit: Sino Biological US Inc.
Learn more about Sino's reagents here!